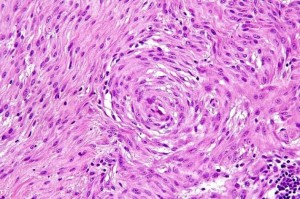

Sarcomes des tissus mous chez le chien : facteurs pronostiques
Les pathologistes du laboratoire vétérinaire LAPVSO ont lu pour vous
Prognostic factors for Cutaneous and Subcutaneous Soft tissue sarcomas in Dogs
M.M. Dennis, K.D. McSporran, N.J. Bacon, F.Y. Schulman, R.A. Foster and B.E. Powers Vet Pathol, 2011, Jan, 48(1):73-84.
Les facteurs pronostiques des sarcomes des tissus mous, cutanés et sous-cutanés, chez le chien
Les Sarcomes des Tissus Mous (STM) sont des tumeurs mésenchymateuses issues des tissus conjonctifs ou tissus mous; ils se développent dans n’importe quelle localisation corporelle, mais fréquemment dans la peau et les tissus sous-cutanés.
Les STM représentent entre 8 et 15% de toutes les tumeurs cutanées et sous-cutanées du chien. Ils se développent particulièrement chez les chiens d’âge moyen et chez les vieux chiens, de races moyennes à grandes.
Elles sont considérées comme ayant un bon pronostic global, (médiane de survie entre 1013 jours et 1416 jours, selon les études) avec un risque de récidive faible (variant de 7 à 30% selon les études).
Néanmoins, en dépit de ce pronostic globalement favorable, les STM regroupent en réalité des tumeurs dont le comportement biologique est variable; le principal problème est donc de parvenir à définir les critères permettant d’identifier les quelques tumeurs au comportement agressif et/ou au risque de métastase élevé, ceci afin d’adapter au mieux la stratégie thérapeutique (chirurgie agressive, thérapeutique adjuvante ou non…).
Les auteurs font le point sur la nomenclature des STM, et passent en revue de façon critique les données publiées jusqu’à maintenant. Ils proposent ensuite un système de grading et tentent d’élaborer un consensus dans l’approche de ces tumeurs.
Nomenclature
Les auteurs soulignent que les STM du chien constitutent en réalité un groupe d’exclusion. Certains sarcomes des tissus mous, plus facilement identifiables et au comportement biologique mieux défini, sont exclus de ce groupe. Il s’agit:
- Des sarcomes histiocytaires
- Des lymphangiosarcomes
- Des hémangiosarcomes
- Des synoviosarcomes
- Des léïomyosarcomes
- Des rhabdomyosarcomes
- Des fibrosarcomes de la cavité buccale
- Des tumeurs de la gaine des nerfs périphériques du plexus brachial (PNST peripheral nerve sheath tumors, aussi dénommées schwannomes, neurofibromes ou tumeurs de la gaine des nerfs
Les tumeurs regroupées dans le groupe des STM incluent des tumeurs pour lesquelles le tissu d’origine est difficile à déterminer et qui présentent généralement des caractéristiques architecturales communes, les rendant difficiles à différencier les unes des autres. Ce groupe inclut donc :
- Des PNST (en dehors de ceux dérivant du plexus brachial)
- Des fibrosarcomes
- Des myxosarcomes
- Des liposarcomes
- Des tumeurs de la paroi vasculaire
- Des sarcomes pléomorphes (aussi dénommés histiocytomes fibreux malins)
- Des mésenchymomes malins
- Des sarcomes indifférenciés
Les auteurs soulignent que pour le moment, il n’existe pas de marquages immunohistochimiques utilisables en routine, capables de différencier facilement les tumeurs les unes des autres.
Cette difficulté d’identification explique la multiplicité des termes employés par les pathologistes pour nommer une même tumeur. On peut citer les termes d' »hémangiopéricytome », de « tumeur de la paroi vasculaire », de « sarcome à cellules fusiformes », de « tumeur à cellules fusiformes des tissus mous » voire de « tumeur de la gaine des nerfs ».
Les auteurs soulignent l’absence de consensus actuel quant à la nomenclature de ces tumeurs.
Les limites rencontrées par les études pronostiques
Les auteurs se sont ensuite attachés à passer en revues les données bibliographiques existantes. Leur analyse est sans appel et ils concluent à une absence de données réellement fiables quant à l’évaluation des facteurs pronostiques des STM du chien.
Selon les auteurs, les principaux des défauts des études menées jusqu’à présent incluent :
- Des études uniquement rétrospectives
- Des effectifs réduits
- De nombreux et différents biais de recrutement
- L’utilisation de données issues d’études dont l’objectif n’était pas initialement l’évaluation de facteurs pronostiques (étude d’efficacité de différents traitements notamment)
- Un trop grand nombre de variables étudiées
- Une faible fiabilité de l’évaluation de la présence ou non de métastases (pas d’autopsie et/ou d’analyse histologique notamment)
- L’étude d’un unique facteur pronostique
Les auteurs soulignent donc la nécessité de mener des études plus approfondies sur les facteurs pronostiques et de suivre une méthodologie rigoureuse et parfaitement définie.
Facteurs pronostiques
Les auteurs passent ensuite en revue les différents facteurs pronostiques considérés jusqu’ici comme pertinents :
- Type histologique
- Ampleur de l’exérèse chirurgicale et qualité des marges d’exérèse à l’histologie
- Grade histologique
- Index mitotique et marqueurs de prolifération
- Récidive locale
- Dimensions de la tumeur
- Localisation anatomique de la tumeur
- Mobilité de la tumeur
- Densité de la micro-vascularisation intra-tumorale
Leur conclusion est qu’aucun facteur pronostique ne peut prédire à lui seul le comportement d’une tumeur, ni déterminer le choix de la conduite thérapeutique à tenir, à l’exception de l’index mitotique qui semble représenter à lui seul un facteur prédictif négatif sur le temps de survie. Là encore, les effectifs utilisés dans les études étant faibles, les données précises devront être confirmées. L’index mitotique ne permettant pas en revanche d’évaluer à lui seul le risque de récidive, ils préconisent donc l’utilisation d’un grading histologique.
Ils soulignent également que la faible reproductibilité des études quant à l’appréciation des marges d’exérèse, le terme de marges « proches » ou « étroites » étant par exemple utilisé de façon très diverse et recouvrant des marges allant de moins d’1 mm à 10 mm…
Le grading de Trojani tient compte de:
- La différenciation
- De l’Index Mitotique (IM)
- De la nécrose
Ce grading des STM du chien a déjà été utilisé et permet de disposer de quelques données préliminaires. Les auteurs soulignent là encore que les données ne sont que parcellaires ou issues d’effectifs limités et invitent donc à prendre ces données avec beaucoup de précaution.
Grade I
Fréquence : la majorité des STM du chien gradés de la sorte semblent correspondre à des grades I.
Récidive locale : les grades I semblent présentent un faible taux de récidive locale après exérèse chirurgicale, mais ce taux est également étroitement dépendant de la qualité de l’exérèse chirurgicale. Le risque est pour le moment évalué à 7% avec des marges chirurgicale étroites.
Métastases : les grade I semblent peu métastaser. Le risque métastatique varie de 7 à 13% selon les études et les métastases se localisent apparemment principalement aux nœuds lymphatiques et aux poumons.
Grade II
Fréquence : les grades II surviennent avec une fréquence intermédiaire.
Récidive locale : Les grades II avec des marges étroites d’exérèse chirurgicale ont un risque de récidive locale de 35% et une rémission plus courte.
Métastases : le risque métastatique varie de 7 à 33%.
Grade III
Fréquence : les grades III semblent moins fréquents : ils représenteraient entre 7 à 17% des STM du chien sous-cutanés et cutanés.
Récidive locale : ils sont considérés comme présentant un risque plus important de récidive locale et de métastase. Mais les chiffres restent imprécis compte-tenu du faible nombre de cas étudiés.
Les grades III avec des marges étroites d’exérèse chirurgicale auraient un risque de récidive locale de 75%.
Il est toutefois nécessaire de conduire des études comportant un plus grand nombre de cas.
Métastases : le taux de métastase pour les grades III n’a pas été précisément évalué, mais apparaît plus élevé que celui des grades I et II: leur risque métastatique est évalué entre 22 à 44%
Les auteurs rappellent que la faible taille des effectifs étudiés, que l’absence de détection précise d’une extension métastatique chez les animaux atteints, qu’une durée trop courte de suivi de ces animaux, peuvent considérablement affecter l’évaluation statistique de la survie des animaux, et ne pas autoriser la perception de risques significativement différents de récidive locale entre les différents grades histologiques. Ainsi, en dépit d’un risque métastatique non négligeable pour les STM de grade III, les auteurs soulignent que leur absence de répercussion sur la survie des animaux atteints pourrait s’expliquer par le fait que les STM sont des tumeurs de croissance lente, qui peuvent être gérées localement sans affecter la qualité de vie de l’animal, que les métastases sont également lentes à se développer et peuvent donc ne pas affecter la survie. Les animaux concernés sont le plus souvent âgés et susceptibles de décéder d’autres causes avant que des récidives locales ou des métastases ne surviennent et n’entraînent une issue fatale.
Quelle reproductibilité de ce grading ?
Les auteurs soulignent que la détermination du grade histologique d’un STM est en soi une analyse subjective, sujette à des variations à la fois pour un même observateur, mais également d’un observateur à un autre, ce qui entrave la transposition des résultats des études de recherche, à la pratique clinique courante et que donc la reproductibilité de ce grading chez le chien reste à démontrer notamment en ce qui concerne l’appréciation du score de différenciation.
Proposition d’un guide d’utilisation de ce grading chez le chien
Les auteurs de l’article proposent un guide pour améliorer la reproductibilité de ce grading chez l’animal :
- Les zones soumises au grading doivent être bien fixées, non inflammatoires, ni hémorragiques
- L’IM doit être le nombre de mitoses pour 10 HPF (x400) mesuré dans la portion la plus cellulaire de la tumeur et la plus mitotique. Si le nombre atteint est proche du seuil il faut recommencer pour confirmer le score obtenu. On doit éviter les zones nécrotiques, hypocellulaires ou ulcérées (Fig1).

Fig 1 : Chien, STM sous-cutané, score mitotique : nombreuses figures mitotique pour ce sarcome, score 3 pour 10 champs HPF (HE X 400).
- La nécrose doit être différenciée des remaniements mucineux, hyalins, hémorragiques ou traumatisés par la chirurgie ou la technique biopsique (Fig 2)
- L’appréciation du critère « différenciation » est une combinaison entre le type histologique et la vraie différenciation. Habituellement le type hisitologique d’une tumeur est déterminé par l’architecture et apprécié au faible grossissement (cf Tableau I pour les types histologiques classiques)
- Si un type histologique est reconnu, il s’agit soit d’un score 1 (bien différencié) (Fig 3,6,8,11) soit d’un score 2 (peu différencié) (Fig 4,7,9,12). Les tumeurs bien différenciées sont celles qui ressemblent le plus au tissu mésenchymateux adulte mature (Fig 3,6,8,11). Au contraire, les tumeurs peu différenciées ont peu de ressemblance avec le tissu mésenchymateux mature normal, même si elles peuvent être d’un type histologique particulier. Si le type d’une tumeur ne peut être établi ou si l’architecture de la tumeur est difficile à identifier, il s’agira d’une tumeur indifférenciée par définition et de score 3 (Fig 5,10). Les auteurs insistent sur le fait que le score de différenciation n’a rien à voir avec une histogenèse incertaine (ainsi si les tumeurs péri-vasculaires ou les PNSTs ont une histogenèse encore controversée, mais elles ressemblent néanmoins à un tissu mésenchymateux mature normal et ne doivent pas systématiquement se voir attribuer le score de 3 si leur architecture typique est correctement identifiable).

Fig 3 : Chien, STM sous-cutané, score de différenciation 1 : faisceaux entrelacés de cellules fusiformes entremêlés de fibres de collagène, suggérant un phénotype fibroblastique/fibrocytique avec une grande ressemblance avec le tissu adulte normal (HE X400)

Fig 4 : Chien, STM sous-cutané, score de différenciation 2 : faisceaux entrelacés de cellules fusiformes entremêlés de fibres de collagène, suggérant un phénotype fibroblastique/fibrocytique mais la ressemblance avec le tissu adulte normal est moins nette (HE, X 200)

Fig 5 : Chien, STM sous-cutané, score de différenciation 3 : faisceaux entrelacés de cellules fusiformes selon un agencement en arêtes de poisson compatible avec un phénotype fibroblastique/fibrocytique mais la ressemblance avec le tissu adulte normal est absente et le type histologique ne peut être affirmé (HE, X400)

Fig 6 : Chien, STM sous-cutané, score de différenciation 1 : cellules rondes au cytoplasme ballonnisé suggérant avec un phénotype lipoblastique/adipocytaire avec une grande ressemblance avec un tissu adipeux adulte (HE x200)

Fig 7 : Chien, STM sous-cutané, score de différenciation 2 : cellules rondes au cytoplasme ballonnisé compatible avec un phénotype lipoblastique/adipocytaire avec une ressemblance moins évidente avec un tissu adipeux adulte (HE X400)

Fig 8 : Chien, STM sous-cutané, score de différenciation 1 : cellules fusiformes à disposition palissadique des noyaux et agencements neuroïdes suggérant avec un phénotype schwannien (gaine des nerfs périphérique) avec une grande ressemblance avec la gaine d’un nerf périphérique normal (HE x200)

Fig 9 : Chien, STM sous-cutané, score de différenciation 2 : cellules fusiformes à disposition palissadique des noyaux (type Antoni A), compatible avec un phénotype schwannien (gaine des nerfs périphérique) mais avec une ressemblance moins nette avec la gaine d’un nerf périphérique normal (HE X200)

Fig 10 : Chien, STM sous-cutané, score de différenciation 3 : cellules fusiformes à disposition palissadique des noyaux compatible avec un phénotype schwannien (gaine des nerfs périphérique) mais sans vraie ressemblance avec la gaine d’un nerf périphérique normal et dont le type histologique précise ne peut être affirmé (HE x200)
Fig 11 : Chien, STM sous-cutané, score de différenciation 1 : cellules fusiformes à tourbillonnante périvasculaire en bulbe d’oignon suggérant avec un phénotype périvasculaire pariétal ou périnerveux avec une grande ressemblance avec les tissus mous normaux périvasculaires ou périnerveux (périnèvre) (HE X 200)

Fig 12 : Chien, STM sous-cutané, score de différenciation 2 : cellules fusiformes tourbillonnante périvasculaire en bulbe d’oignon compatible avec un phénotype périvasculaire pariétal ou périnerveux avec ressemblance moins évidente avec les tissus mous normaux périvasculaires ou périnerveux (périnèvre) (HE X100)
Les auteurs soulignent que, pour mieux clarifier les corrélations existant entre « grade histologique » et « risque métastatique », il est nécessaire de conduire des études statistiques complémentaires reposant sur un protocole de suivi détectant et confirmant la survenue de métastases, c’est-à-dire s’appuyant sur un examen histologique post-nécropsique ou de biopsies tissulaires et non uniquement sur un examen clinique et sur l’imagerie médicale ou des examens cytologiques, qui peuvent conduire à surestimer le risque métastatique.
De même, les animaux perdus de vue, l’absence d’autopsie et l’absence de suivi suffisamment long peut sous-estimer ce risque métastatique et ce biais est tout particulièrement à craindre en matière de STM dont l’évolution métastatique peut être plus longue à se manifester (après 3 ans d’évolution par exemple), les métastases pouvant en outre n’avoir aucune manifestation cliniquement détectable et demeurer silencieuses. Ces études devront également évaluer clairement la relation entre survie et métastases.
Les auteurs estiment que les pathologistes doivent, dans le compte-rendu histologique d’une STM, s’attacher à déterminer les facteurs pronostiques suivants :
- Le type histologique
- Le grade histologique
- L’index mitotique
- La qualité des marges d’exérèse chirurgicales
Cependant les caractéristiques histo-morphologiques énoncés dans le Tableau I peuvent être utilisées.
L’index mitotique, parce qu’il donne des informations sur la survie, doit toujours être chiffré dans le compte-rendu histologique.
Le grade histologique est toutefois plus instructif en ce qui concerne la probabilité de récidive locale.
L’IM ne doit pas être substitué au grade histologique.
Des méthodes standard de recoupe macroscopique doivent être définies (certaines méthodes sont en cours d’évaluation, les auteurs citant notamment les travaux de Kamstock et al (2011) (2).
Les auteurs estiment que pour une interprétation correcte des marges d’exérèse chirurgicale, il faut éviter les termes qualitatifs ambigus de « marges étroites », « marges complètes » et s’efforcer de les substituer à leur chiffrage précis (en donnant la distance minimale entre les cellules néoplasiques et les marges chirurgicales de la masse). Si on les emploie malgré tout, les auteurs recommandent de suivre les définitions suivantes:
- Marges incomplètes : des cellules tumorales sont visibles sur au moins une des marges d’exérèse chirurgicale
- Marges étroites : la distance entre les cellules tumorales et les marges d’exérèse chirurgicale est < 3 mm ou les marges d’exérèse ne comporte pas d’autre tissu sain que la pseudo-capsule périphérique.
- Marges complètes (saines) : la distance entre les cellules tumorales et les marges d’exérèse chirurgicale est > 3 à 5 mmm.
Les auteurs conseillent également de préciser la nature des tissus constituant ces marges (tissu adipeux, fibreux, tissu nécrotique ou inflammatoire).
Les auteurs déconseillent aux pathologistes de fournir des taux précis de risque de récidive locale comme de risque métastatique, puisque les données citées sont tirées d’études encore statistiquement imparfaites. Ils fournissent les données du Tableau III, qui ne permettent hélas qu’une appréciation très vague de ces risques.
Les auteurs concluent que :
Les recherches suggèrent que le grading histologique, l’index mitotique et la qualité des marges d’exérèse chirurgicale pourraient servir d’outils pronostiques.
Des marges saines d’exérèse chirurgicale prédisent une absence de récidive locale.
Le risque de récidive locale augmenterait avec le grade histologique.
L’extension métastatique est a priori rare pour les grades I et II et plus probable pour les grades III.
Un index mitotique élevé (>9 pour 10 HPF High Power Field) est synonyme d’un temps de survie réduit.
Les auteurs soulignent à nouveau la nécessité d’études statistiques complémentaires :
- Pour établir la corrélation entre le temps de survie et le degré de résection chirurgicale ou la qualité des marges d’exérèse chirurgicale
- Pour déterminer quels sont les risques précis de récidive locale en fonction de la qualité de ces marges
- Pour asseoir des méthodes valables d’évaluation des marges
- Pour déterminer les potentiels métastatiques et les médianes de survie propres à chaque grade histologique
- Pour diagnostiquer précisément le type histologique afin de déterminer s’il est pertinent de continuer à étudier les STM en tant que groupe de tumeurs
- Pour déterminer l’utilité éventuelle d’autres critères (marqueurs de prolifération, volume ou taille tumorale, localisation tumorale, type histologique, infiltration ou degré d’invasion, profil cytogénétique) en tant qu’outils pronostiques
Les auteurs espèrent voir à l’avenir se développer des techniques innovantes comme la biologie moléculaire pour pouvoir disposer de nouveaux outils à valeur pronostique pour les STM du chien comme cela est le cas pour les STM de l’homme.
Extrait du Tableau I de l’article : Quelques critères distinctifs de différenciation parmi les STM du chien
| Type | Tissu d’origine Histogenèse | Phénotype | Caractéristiques histologiques |
|---|---|---|---|
| Fibrosarcome | Tissu fibreux | Fibroblaste, fibrocyte | Faisceaux cellulaires en arêtes de poisson, stroma collagène |
| Fibrosarcome chéloïdien Myxosarcome |
Tissu fibreux | Fibroblaste, fibrocyte | Stroma collagène hyalinisé Cellules fusiformes ou étoilées baignant dans un stroma mucineux |
| Liposarcome | Tissu adipeux | Lipoblaste, adipocyte | Cellules polyédriques au cytoplasme vacuolisé |
| Tumeurs périvasculaires pariétales (t.glomiques, hémangiopéricytomes, myopéricytomes, angioléïo-myomes ou –sarcomes,angiomyofibroblastome, angiofibrome) | Cellules des parois vasculaires | Architecture de type vasculaire avec lacunes vasculaires en bois de cerf, faisceaux cellulaires en spirales péri-vasculaires en bulbes d’oignons ou faisceaux mimant une média vasculaire | |
| Tumeur de la gaine des nerfs périphériques (PNST) (schwannome ou neurofibrosarcome) | Nerf périphérique | Cellule de Schwann, neurofibroblaste | Faisceaux cellulaires entrelacés en spirales autour des fibres de collagène, palissades agencements cellulaires de type Antoni A et Antoni B |
| Sarcome pléomorphe (fibro-histocytome malin) | Tissu fibreux | Cellule mésenchymateuse primitive | Agencement storiforme de cellules fibroblastiques,de cellules histiocytoïdes caryo ou cyto-mégaliques plurinucléées et d’un nombre varié de cellules inflammatoires |
| Mésenchymome | Toute cellule mésenchymateuse | Types cellulaires multiples | Cellules mésenchymateuses de plusieurs types tissulaires avec matrice variée incluant collagène, os ou cartilage |
| Léïomyosarcome | Muscle lisse | Cellule musculaire lisse | Noyau en cigare, cytoplasme abondant |
| Rhabdomyosarcome | Muscle squelettique | Cellule musculaire squelettique myoblaste ou myocyte | Striations cytoplasmiques, cellules en raquettes ou rubannées |
Extrait du Tableau II de l’article : Système de grading histologique pour les STM cutanés et sous-cutanés du chien d’après Trojani et al (1).
| Score de différenciation | |
|---|---|
| 1 | Sarcomes qui ressemblent à un tissu adulte normal, par type Ex : liposarcome bien différencié, tumeur de la gaine des nerfs bien différenciée… |
| 2 | Sarcomes pour lesquels le diagnostic de type histologique est certain, en dépit d’une mauvaise différenciation Ex : liposarcome peu différencié, tumeur de la gaine des nerfs périphérique peu différenciée |
| 3 | Sarcomes indifférenciés, sarcomes pour lesquels le type histologiques est incertain |
| Score mitotique : sur 10 champs au fort grossissement à l’objectif 40 | |
| 1 | 0-9 |
| 2 | 10-19 |
| 3 | > 19 |
| Score de nécrose | |
| 1 | Pas de nécrose |
| 2 | Moins de 50 % de nécrose tumorale |
| 3 | Plus de 50 % de nécrose tumorale |
| Grade histologique : on additionne les scores de différenciation, mitotique et de nécrose | |
| Grade I | ≤ 3 |
| Grade II | 4 – 5 |
| Grade III | ≥ 6 |
Extrait du Tableau III de l’article : pronostic des STM canins sous-cutanés et cutanés en fonction du grade histologique et de la qualité des marges d’exérèse chirurgicale
Marges étroites* : la distance entre les cellules tumorales et les marges d’exérèse est < 3 mm ou les marges d’exérèse ne comporte pas d’autre tissu sain que la pseudo-capsule périphérique de la tumeur
Marges complètes** : la distance entre les cellules tumorales et les marges d’exérèse est > 3 à 5 mmm
Aucun risque précis ni de récidive locale, ni métastatique, n’a été évalué en corrélation avec le grade histologique et la qualité des marges d’exérèse chirurgicale.
| Evolution | Grade I | Grade II | Grade III |
|---|---|---|---|
| Métastases | Rare | Rare – peu fréquent | Grande propension à métastaser |
| Récidive locale | |||
| Marges étroites* | Peu fréquent | Fréquence intermédiaire | probable |
| Marges complètes** | Rare | Rare | Minorité de cas |
Références bibliographiques à retenir
- Trojani M, Contesso G, Coindre JM, Rouesse J, Bui NB, de Mas- carel A, Goussot JF, David M, Bonichon F, Lagarde C: Soft-tissue sarcomas of adults: study of pathological prognostic variables and definition of a histopathological grading system. Int J Cancer 33:37–42, 1984.
- Kamstock DA, Ehrhart EJ, Getzy DM, et al: Recommended guidelines for submission, trimming, margin evaluation and reporting of tumor biopsy specimens in veterinary surgical pathol- ogy. Vet Pathol 48(1) 19-31.
Commentaires & remarques de lecture de l’article :
Le grading histologique de Trojani et al (1980) place en score de différenciation 3 les sarcomes indifférenciés et les sarcomes peu différenciés dont le diagnostic de type histologique n’est pas certain et donc contestable, mais également des sarcomes qui sont exclus du groupe des STM cutanés et sous-cutanés du chien défini par la nomenclature de cet article, par exemple les rhabdomyosarcomes et les synovialosarcomes.
Le terme « sarcome des tissus mous » n’est donc pas utilisé de la même façon chez le Chien et chez l’Homme.
Il précise aussi quelle doit être la technique rigoureuse de comptage des mitoses (d’après Tumeurs des Tissus Mous – Groupe Sarcomes FNCLCC, Tome II – 2004, Facteurs pronostiques des sarcomes des tissus mous, 493-511) que ne rappelle pas en détail l’article :
Le grading ne doit pas remplacer le diagnostic de type histologique : il ne permet en aucun cas de différencier une lésion bénigne d’une tumeur maligne et, avant de grader une tumeur des tissus mous, le pathologiste doit être sûr de sa malignité. En effet, des lésions bénignes pseudosarcomateuses, telles les fasciites nodulaires ou prolifératives présentent souvent des signes histologiques de malignité, tel un index mitotique élevé, et si on leur appliquait le grading elles pourraient être de haut grade.
Le grading n’est pas applicable à tous les sarcomes. Sa valeur pronostique a été démontrée pour les sarcomes des tissus mous de l’adulte chez l’Homme.
Le grading doit être établi sur la tumeur primitive non traitée. En effet, une radiothérapie et/ou une chimiothérapie peuvent augmenter la nécrose, diminuer l’index mitotique et même induire des modifications dans la différenciation.

